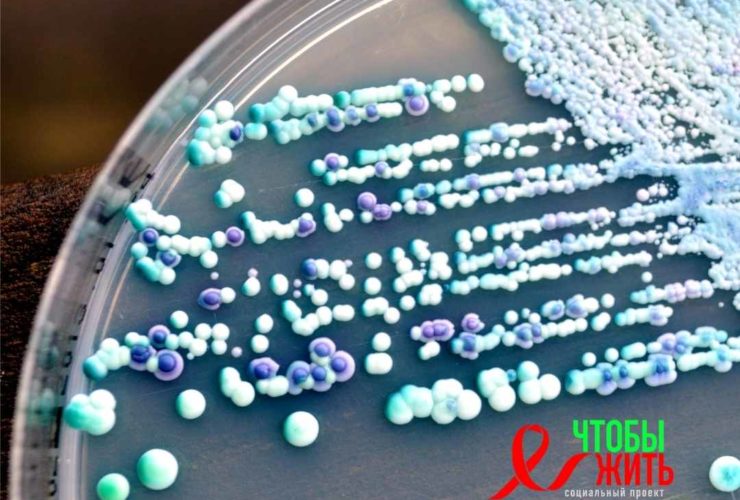

Команда ученых разработала, новый метод который может обеспечить точную оценку вирусной нагрузки ВИЧ на уровне или выше примерно 2000 копий вируса на миллилитр крови и является менее дорогостоящим чем метод ПЦР. ...
Новое исследование показало что прополис демонстрирует благотворное влияние на людей, живущих с ВИЧ, вирусом, вызывающим СПИД. ...
Новый подход позволит избежать любого воздействия на здоровые неинфицированные клетки, которые сохраняют нормальную функцию гена MOGS. Стимуляция аппарата в клетках, инфицированных ВИЧ-1, нарушала гликановую структуру белка оболочки ВИЧ-1, что приводило к образованию неинфекционных вирусных частиц. ...
21 мая 2023 года - Всемирный день памяти жертв СПИДа. Впервые мероприятия в честь памятной даты прошли в Сан-Франциско в 1983 году, а в 1991 году художник Фрэнк Мур создал символ движения – красную ленту. Теперь этот день памяти проходит ...
Укол иглой от шприца на улице – это неприятный и опасный случай, который может произойти с каждым из нас. Но что делать, если такое произошло? Какие меры нужно принять, чтобы минимизировать риск заражения инфекционными заболеваниями? В этой статье мы расскажем, ...
Вирус папилломы человека (ВПЧ) и вирус иммунодефицита человека (ВИЧ) - это вирусы, которые в основном распространяются в результате полового контакта. Хоть и у них разные симптомы, наличие ВИЧ может сделать кого-то более восприимчивым к потенциальным заболеваниям, таким как предрак и ...
В этой статье рассматривается связь между кандидозом и ВИЧ, также рассматривается, как лечить кандидозные инфекции, которые развиваются на половых органах, ротовой полости, горле и пищеводе. ...
Ложный результат - это когда человек, при прохождении теста получает результат не соответствующий реальному статусу, например не инфицированный вирусом, получает положительный результат теста. Человек, прошедший тестирование на ВИЧ, может получить ложноположительный результат из-за ошибок допущенных при проведении теста, наличия других ...
Термин «нулевой пациент» обычно относится к человеку, идентифицированному как первоначальный носитель инфекционного заболевания во вспышке связанных случаев. В случае ВИЧ трудно идентифицировать нулевого пациента, так как люди могли получить инфекцию до того, как врачи начали наблюдение за болезнью. ...
В новом исследовании людей, живущих с ВИЧ, исследователи обнаружили, что нейтрофилы, играют роль в нарушении функций и количества Т-клеток, а также в связанном с этим хроническом воспалении, которое является общим для ВИЧ-положительных. ...